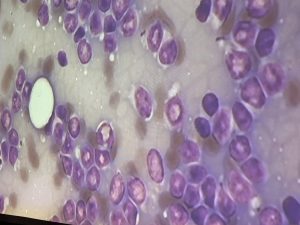

最近ニュースでも聞くことのあるSFTS(重症熱性血小板減少症候群)に関して院内セミナーを行いました。
SFTSは寄生虫のマダニが媒介する感染症ですが、ヒト・イヌ・ネコを含めた多くの哺乳動物に感染する非常に致死率が高い病気になっています。
まだ、分かっていない事も多い病気ですが、今できることはとにかく予防することになります。
徹底的にマダニ・ノミの予防をしていきましょう。
ご興味のある方も多いと思いますので、8月中に飼い主様のためのセミナーも開催予定です。準備ができましたらお知らせいたしますのでお待ちください。(滝沢)